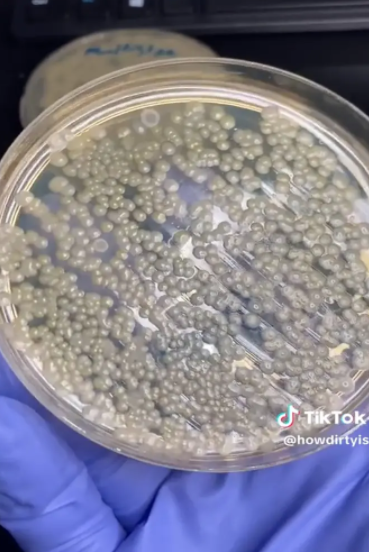
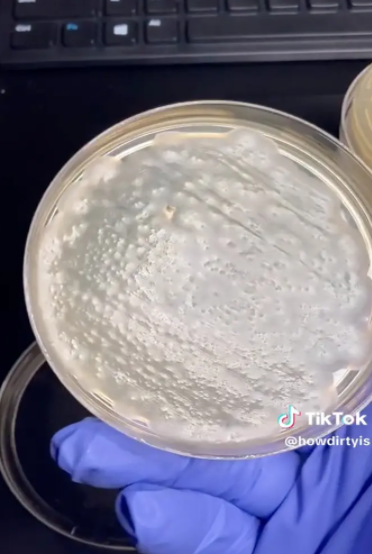

大家平常应该没少去丝芙兰店里试用化妆品吧? 可能很多人也都知道,这些试用品基本上都很脏,但是不试用一下,又不能确定到底适不适合自己,所以大部分时候,也就睁一只眼闭一只眼了。

不过这段在网上爆火的丝芙兰化妆品细菌测试,可能会让你劝退...
近期,一位TikTok博主@howdirtyis发布了一段检测丝芙兰化妆品试用品的视频,想让大家看看这些试用品到底有多脏。 在这项实验中,她用棉签擦拭了口红、腮红、眼影和睫毛膏等样品,结果也是令人难以置信。 
视频的标题中写道:“丝芙兰的那些试用品到底有多脏?”
在收集完样本后,博主就将其挨个放在有标签的培养皿中擦拭,然后将培养皿放在一边,让细菌生长。 过了一段时间再去看,粉底棒的培养皿几乎完全被细菌给覆盖了,可以说是所有样品中情况最严重的。
当然了,腮红和眼影盘也并没有好到哪去,培养皿里也是布满了细菌。 “这上面有各种各样的东西。” 不过让人诧异的是,遮瑕膏似乎并没有细菌生长,口红和睫毛膏也是如此。 
要知道,这段视频一经发布,点击量就超过了340万,大家也都对检测结果感到很震惊。 “说实话,遮瑕膏和睫毛膏的结果确实让人很意外。”
还有一个人写道:“作为曾经在丝芙兰工作过的人,比起粉末状产品,我们确实会更频繁地清洁和更换口红、眼线笔和睫毛膏。”
 其实早在2018年,大多伦多地区多家美容店的化妆品测试人员就曾检测过试用品中的金黄色葡萄球菌和霉菌。
市场生产商在Shoppers Drug Mart、丝芙兰(Sephora)、The Body Shop和MAC Cosmetics等化妆品店卧底,采集了60种睫毛膏、唇膏、腮红、口红和眼影试用品,然后将它们送到微生物实验室。

据加拿大广播公司报道,实验室发现40%的样品含有金黄色葡萄球菌,28%的样品有霉菌生长。
据梅奥诊所称,葡萄球菌会引起感染,包括皮肤上的疖子和食物中毒。 所以大家之后试用这些化妆品时,也一定要谨慎一些,毕竟细菌防不胜防!
|